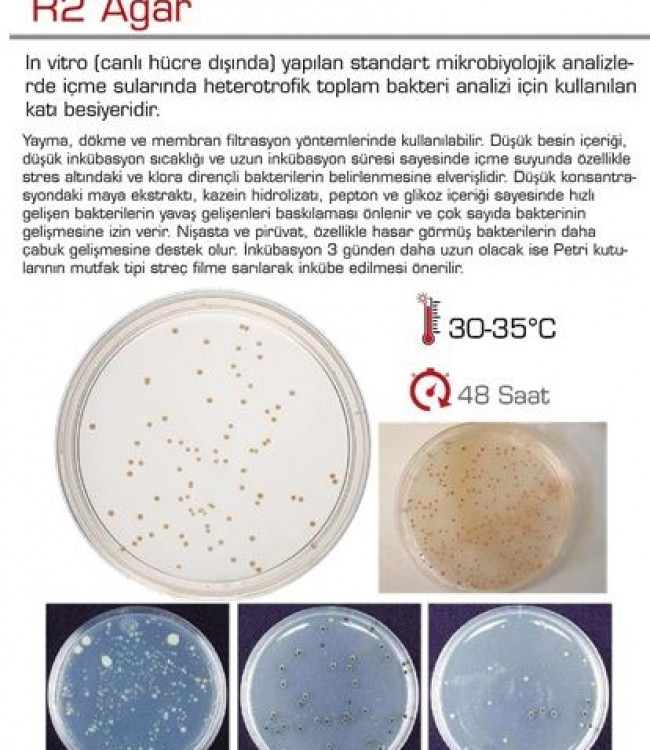
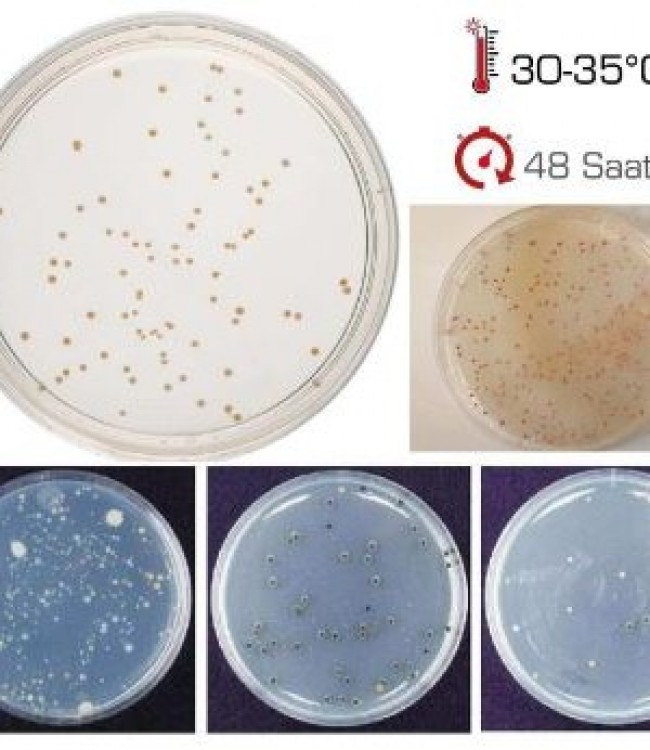

R2 Agar
R2 Agar
ln vitro [canlı hücre dışında] yapılan standart mikrobiyolojik analizlerde içme sularında heterotrofik toplam bakteri analizi için kullanılan katı besiyeridir.
Yayma, dökme ve membran filtrasyon yöntemlerinde kullanılabilir.
Düşük besin içeriği düşük inkübasyon sıcaklığı ve uzun inkübasyon süresi sayesinde içme suyunda özellikle stres altındaki ve klora dirençli bakterilerin belirlenmesine elverişlidir.
Düşük konsantrasyondaki maya ekstraktı, kazein hidrolizatı, pepton ve glikoz içeriği sayesinde hızlı gelişen bakterilerin yavaş gelişenleri baskılaması önlenir ve çok sayıda bakterinin gelişmesine izin verir.
Nişasta ve pirüvat, özellikle hasar görmüş bakterilerin daha çabuk gelişmesine destek olur.
İnkübasyon 3 günden daha uzun olaçak ise Petri kutularının mutfak tipi streç filme sarılarak inkübe edilmesi önerilir.